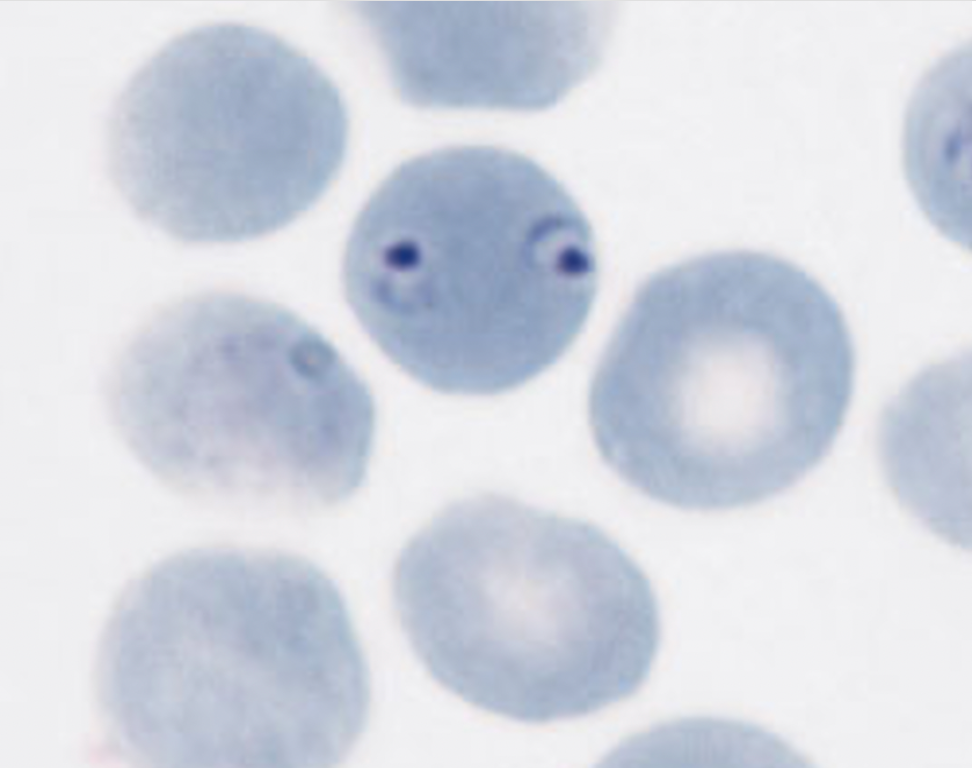

Describe the process for the water quality tests: Presumptive and Confirmed coliform.
Presumptive: add water samples to phenol red lactose broth.
Confirmed: Inoculate an EMB plate with broth from the tubes that produced acid and gas.
Dark growth with a metallic sheen is a probable coliform.

candida
Describe the procedures used for an indirect and a direct (sandwich) ELISA.
- Either the antibody (direct) or antigen (indirect) is stuck to the bottom of the well.
- Add sample, wait, then wash
- add antibody solution, wash
- add color reagent
Direct: antibody, antigen, antibody
Indirect: antigen, antibody, antibody

taenia

Schistosoma

enterobius
plasmodium
Motility structures of protozoa
Cilia and flagella
Know what the results of a positive MR and VP tests would look like and what products in general are produced by a positive result. At what pH (acidic or basic) is “methyl red” red. What sugar is fermented in these tests?
Positive MR result: Red broth
Positive VP result: Red broth
Acids are produced in a positive result
Methyl red is red at a acidic pH
Glucose is fermented
Describe how to set up a Kirby-Bauer (disk diffusion) antibiotic susceptibility test. Describe what is meant by confluent growth and how we “seed” a plate. Know what is meant by the zone of inhibition and know how it is measured.
Inoculate the entire plate and lay labeled antibiotic disks on the lawn. The zone of inhibition indicates sensitivity to antibiotics and is measured in millimeters across the diameter of the zone.

giardia
Describe how an ELISA is different from the Western blot technique.
No electrophoresis in ELISA

trichomonas

taenia

rhizopus
What do the letters in SIM stand for and what reaction does each symbolize? What do positive results for the “S” and “M” look like?
S: sulfur reduction
I: Indole production
M: Motility
Positive sulfur is a black tube
Positive motility is a hazy tube

penicillium

entamoeba
Which type and genus of helminths have proglottids and a scolex?
cestode/tape worm
Know what a positive result for indole would look like and what amino acid is broken down to produce indole. What enzyme is present? What reagent is added?
-red layer at the top of tube after adding reagent
-tryptophan
-tryphtohanase
-Kovacs reagent

aspergilllus
Know what is meant by drug synergy and how it could be described.
When two drugs work better in combination than alone

trypanosoma


